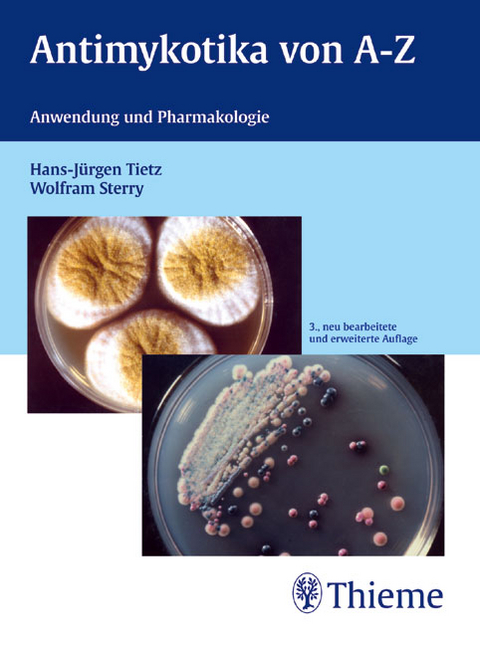
Antimykotika von A-Z - Hans J Tietz, Wolfram Sterry

Antimykotika von A-Z
Anwendung und Pharmakologie auf einen Blick
Seiten
2004
|
3., neubearb. u. erw. Aufl.
Thieme (Hersteller)
978-3-13-137793-7 (ISBN)
Thieme (Hersteller)
978-3-13-137793-7 (ISBN)
- Titel erscheint in neuer Auflage
- Artikel merken
Zu diesem Artikel existiert eine Nachauflage
Das Spektrum der Erkrankungen reicht von den Haut- und Nagelmykosen, speziellen Pilzerkankungen bei Frauen und Kindern bishin zu lebensbedrohlichen Infektionen in der high-tech-Medizin. Ebenso breit gefächert ist das Arsenal an neuen Antimykotika bzw. Neuzulassungen, vom Batrafen S Shampoo mit dem Wirkstoff Ciclopirox bis zum Voriconazol, das Hoffnung bietet, schwerste systemische Mykosen durch Non-C. albicans-Arten und Aspergillen erfolgreicher zu behandeln.
Bedeutende Therapieleitlinien sind auf den aktuellsten Standgebracht worden. Das therapeutische Herangehen an neue Krankheitserreger oder wieder neu auftretende Spezies wurde berücksichtigt.
Die Wirkstoffe werden in alphabetischer Reihenfolge vorgestellt,getrennt nach systemischen und topischen Antimykotika. Übersichtliche Spezialkapitel zur "Therapie ausgewählter Mykosen" schließen sich an.
| Zusatzinfo | 1 Abb. |
|---|---|
| Sprache | deutsch |
| Maße | 120 x 160 mm |
| Gewicht | 150 g |
| Einbandart | kartoniert |
| Themenwelt | Medizin / Pharmazie ► Pharmazie |
| Schlagworte | Antibiotika • Antimykotika • Pilzerkrankung |
| ISBN-10 | 3-13-137793-3 / 3131377933 |
| ISBN-13 | 978-3-13-137793-7 / 9783131377937 |
| Zustand | Neuware |
| Informationen gemäß Produktsicherheitsverordnung (GPSR) | |
| Haben Sie eine Frage zum Produkt? |
